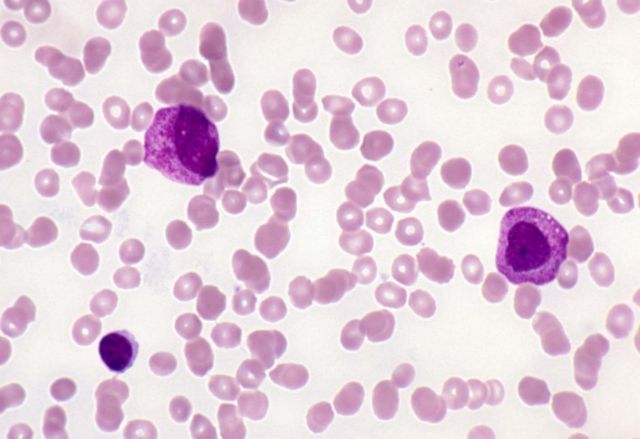

Ο πέμπτος πιο συχνός καρκίνος στην Ευρώπη είναι το λέμφωμα. Πρόκειται για έναν τύπος καρκίνου που μπορεί να αναπτυχθεί όταν προκύψει σφάλμα στη διαδικασία ωρίμασης ενός λεμφοκυττάρου. Αυτό οδηγεί σε ένα μη φυσιολογικό κύτταρο που λόγω του ανεξέλεγκτου, μη φυσιολογικού πολλαπλασιασμού του καθίσταται καρκινικό με μεγάλη ταχύτητα.
Όπως τα φυσιολογικά λεμφοκύτταρα, έτσι και τα καρκινικά λεμφοκύτταρα μπορούν να αναπτυχθούν σε πολλά μέρη του σώματος, συμπεριλαμβανομένων των λεμφαδένων, του σπλήνα, του μυελού των οστών, του αίματος ή άλλων οργάνων.
Τα παραπάνω ανέφεραν ο κ. Θεόδωρος Βασιλακόπουλος, επίκουρος καθηγητής Αιματολογίας, και η πρόεδρος της Πανελλήνιας Ένωσης Σπανίων Παθήσεων κυρία Μαριάννα Λάμπρου με αφορμή την Παγκόσμια Ημέρα Ευαισθητοποίησης για το Λέμφωμα στις 15 Σεπτεμβρίου.
Σύμφωνα με τους ειδικούς, μέχρι στιγμής δεν έχει προσδιοριστεί με ακρίβεια τι προκαλεί την εμφάνιση του λεμφώματος, παρόλο που είναι γνωστό ότι δεν είναι μεταδοτικό και δεν υπάρχουν ενδείξεις ότι πρόκειται για κληρονομικό νόσημα.
Ως πιθανές αιτίες του λεμφώματος έχουν αναφερθεί στη βιβλιογραφία η καταστολή του ανοσοποιητικού συστήματος από φάρμακα ή θεραπευτική ακτινοβολία και σπάνιες ιογενείς λοιμώξεις. Οι πρόσφατες εξελίξεις της τεχνολογίας και των διαθέσιμων θεραπειών κάνουν την αντιμετώπιση του λεμφώματος να είναι ολοένα πιο ελπιδοφόρα. Ορισμένες μορφές της νόσου θεραπεύονται πλήρως, ενώ άλλες ελέγχονται επαρκώς, ώστε η ποιότητα ζωής των ασθενών να μην επηρεάζεται αρνητικά.
«Η υποτροπή είναι ένα καταστροφικό συμβάν για τους ασθενείς με λέμφωμα Hodgkin και τις οικογένειές τους» δήλωσε ο κ. Βασιλακόπουλος. «Εκτός από τον συναισθηματικό αντίκτυπο, ο οποίος είναι σημαντικός, η πρόκληση της θεραπευτικής αντιμετώπισης της νόσου τους καθίσταται πολύ μεγαλύτερη. Είναι σημαντικό για τους αιματολόγους στην Ελλάδα να έχουν στη διάθεσή τους καλά ανεκτές και αποτελεσματικές θεραπευτικές επιλογές που μπορούν να χρησιμοποιηθούν αμέσως μετά την μεταμόσχευση για την μείωση του κινδύνου υποτροπής των ασθενών με λέμφωμα Hodgkin που διατρέχουν αυξημένο κίνδυνο».